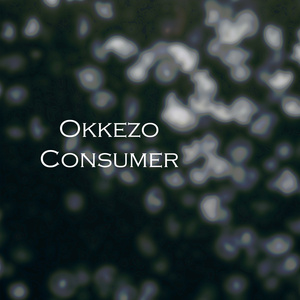
Nanu

ABAKO ASHA RASWAPA
Anil Bista Pyuthani, Mohan Nepali, Laxmi Nepali, Dinesh Thakulla, Om Prakash Rawal, Sajjan Dhami, Sanjaya Shreepal, Anisha Nanu, Govinda Thakulla

Naya Sapana
Anisha Nanu, Anil Bista Pyuthani

MAYA BASYO
Anisha Nanu, Anil Bista Pyuthani

TIMI MERO PRIYASI
Anisha Nanu, Anil Bista Pyuthani

SABAI YAAD CHHA
Anisha Nanu

TIMI BINA BACHNA SAKHCHHU
Anisha Nanu

YE MAYA SUTUKKA BHANA
Anisha Nanu

Nanu
Factory 81

Nanu
Chucho Valdés

Mr Blue
Anisha

Premer Shadhona
Anisha

Nanu
Helene Gjerris, Jeanette Balland, Mathias Reumert

Хороший мальчик
Anisha

Nanu
Chucho Valdés

Nanu
Manoj Kumar M

Break My Heart Again
Anisha

Ghostin
Anisha

i hope ur happier without me
Anisha
Nanu
Okkezo

Nanu
Ilja Glusgal, Suzi Miller

Nanu
Ilja Glusgal, Suzi Miller

nanu
杨在焕

Nanu
Wily Sool

Eid Elo
Anisha

Kurbani
Anisha

Nanu
Siddhraj Zala

Life Eternal
Anisha

Desiree
Anisha

Art
Anisha

The Soldier
Anisha

Nanu
Heal Today

Nanu
Mena Melath

Never Knew
Anisha

Nanu
Chucho Valdés

Nanu
Shi Buka

No.
Anisha

Nanu
dendeweg

Nanu
Vadim Kizilov

NaNu
Merevin

Nanu
Heal Today

Nanu
Lawrence Turner

Sehri Khawar Somoi Holo
Anisha Parveen

All I Want
Anisha

A Million Dreams
Anisha

Instead of Me
Anisha

World Spins
Anisha

Wandering Stars
Anisha